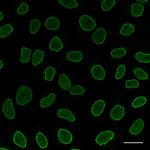
Rabbit IgG Nano (VHH) Secondary Antibody in Immunocytochemistry (ICC/IF)

Search
Invitrogen
Alpaca anti-Rabbit IgG Nano (VHH) Recombinant Secondary Antibody, Alexa Fluor™ 488
{{$productOrderCtrl.translations['antibody.pdp.commerceCard.promotion.promotions']}}
{{$productOrderCtrl.translations['antibody.pdp.commerceCard.promotion.viewpromo']}}
{{$productOrderCtrl.translations['antibody.pdp.commerceCard.promotion.promocode']}}: {{promo.promoCode}} {{promo.promoTitle}} {{promo.promoDescription}}. {{$productOrderCtrl.translations['antibody.pdp.commerceCard.promotion.learnmore']}}
图: 1 / 3
Rabbit IgG Nano (VHH) Secondary Antibody (SA5-10323) in ICC/IF

产品信息
SA5-10323
免疫印迹 (WB)
免疫细胞化学 (ICC/IF)
点杂交 (DB)
免疫电镜技术 (IM)
宿主/亚型
Expression System
分类
类型
克隆号
抗原
偶联物
激发/发射光谱
形式
浓度
规格
保存条件
运输条件
RRID
靶标
抗体形式
产品详细信息
Biclonal nanobodies specific for rabbit IgG Fab and Fc. CTK0101: KD = 0.2 nM, CTK0102: KD = 1.2 nM
Non Cross-Reactivity includes: Mouse, rat, sheep, goat, and guinea pig serum. Cross-reactivity to: Human and macaque serum
Rapid workflow: Simultaneous incubation of rabbit IgG primary antibody and Alpaca anti-rabbit IgG Nano (VHH) recombinant secondary antibody.
Offered through a partnership with ChromoTek.
靶标信息
Anti-Rabbit secondary antibodies are affinity-purified antibodies with well-characterized specificity for rabbit immunoglobulins and are useful in the detection, sorting or purification of its specified target. Secondary antibodies offer increased versatility enabling users to use many detection systems (e.g. HRP, AP, fluorescence). They can also provide greater sensitivity through signal amplification as multiple secondary antibodies can bind to a single primary antibody. Most commonly, secondary antibodies are generated by immunizing the host animal with a pooled population of immunoglobulins from the target species and can be further purified and modified (i.e. immunoaffinity chromatography, antibody fragmentation, label conjugation, etc.) to generate highly specific reagents.
仅用于科研。不用于诊断过程。未经明确授权不得转售。




